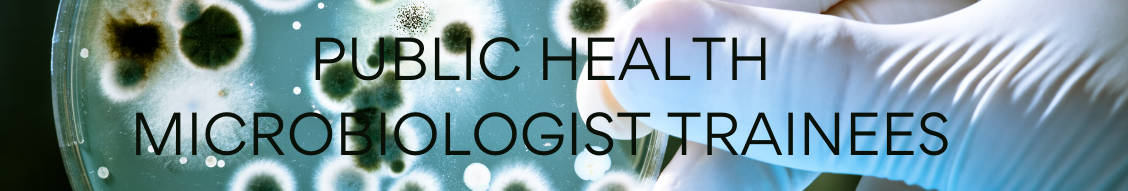

To receive orientation and guidance on the application of laboratory. Click here or press any key to continue.
 Job Announcement Public Health Microbiologist Trainee County Of Solano
Job Announcement Public Health Microbiologist Trainee County Of Solano
Apply to Public Health Nurse Microbiologist Assistant Director and more.

Public health microbiologist trainee jobs. Public Health Microbiologist Santa Cruz Santa Cruz CA. Preventive Medicine Public Health Residency Program. These positions may also be filled at either the Public Health Microbiologist Trainee.
Los Angeles County CA. Redding CA 96001 1 location. One 1 years work experience as a public health microbiologist in an approved laboratory.
The Public Health Microbiologist Trainee is a trainee class for the series. PUBLIC HEALTH MICROBIOLOGIST TRAINEE. You learn safe specimen handling and practice the methods that.
If certified or licensed may draw and examine blood and make qualitative determinations of blood urine and other body fluids. Please be aware that you must request your school to postal mail your official transcript directly to LFS. Applicants who have obtained a Public Health Microbiologist Trainee Certificate from the California StateDepartment of Public Health Laboratory Field Services stating that they meet the minimum educational requirements for admission to the examination for a certificate as a Public Health Microbiologist will be invited to interviews.
43K – 111K Glassdoor est 30d. PUBLIC HEALTH MICROBIOLOGIST II. Need Entry Level Experienced.
Receives instruction and on-the-job training in the performance of standardized public health laboratory tests as a participant in a formal six-month program in an approved training laboratory. The Public Health Laboratory is currently seeking a public health professional to serve as an Associate Laboratory Microbiologist Level II. Conducts and reviews quality control procedures.
County of Monterey CA. A public health microbiologist trainee job focuses on learning to work in a laboratory to test for identify and contain diseases and microscopic organisms that cause health problems. You undergo training under the supervision of experienced public health microbiologists.
Be sure to include the recruitment title Public Health Microbiologist Trainee and the recruitment number 21-331010-E1 in your email or fax. This translates to around 31 per hour so even a part time position offers lucrative rewards. Clinical Microbiologist Scientist Trainee License.
Keeps records and makes reports. Job Opportunities – Laboratory Field Services. Public Health Microbiologist Trainee Government Jobs page has loaded.
Public Health Microbiologist Trainees are expected to attend part of their training at the California Public Health Laboratory in Richmond CA and may also attend trainings at other public health laboratories. Sonoma County Public Health Microbiologist Trainee I II – Extra-Help 1827 – 4287Hourly The County of Sonoma is seeking qualified candidates to fill multiple extra-help temporary Public Health Microbiologist positions in the Public Health Laboratory of the Department of Health Services. Need Entry Level Experienced.
Under direction performs interprets and reports appropriate tests on diagnostic and reference specimens. View Local Openings Apply. Resources log in sign up.
California Certified Public Health Microbiologists PHMs are professional laboratorians who specialize in detecting isolating and identifying the microorganisms that are associated with infectious and communicable diseases. CA 93301 or fax to 661 868-3928. People who searched for Public Health Microbiologist jobs in California also searched for research microbiologist research molecular biologist entry level microbiologist molecular biologist microbial ecology orthopedic research assistant research biologist clinical laboratory scientist microbiology medical technologist microbiology.
Posted 1 week ago Closes in 6 days Share. Assists in training technical and professional personnel in developing procedures in evaluating work of clinical. Full Job Descriptions for.
71686 – 83000 a year Microbiologist- Supv. Ad Apply For The Highest Paid Microbiologist jobs Jobs In Your Area Now. This is the entry and first journey level.
The approximate start date is January 4 2021. Public Health Microbiologist I. Apply Today Start Tomorrow.
Under the close supervision of the Public Health Microbiologist Supervisor Virology within the Rabies and Zoonotic Diseases Unit the Microbiologist Intern MI will function as a Microbiologist Trainee to perform microbiological and similar biological analyses in a training capacity. It differs from the Public Health Microbiologist in that incumbents in this class do not possess a valid Public Health Microbiologist certificate issued by the California State Department of Health. Los Angeles County Department of Human Resources 41.
Will be conducted for the purpose of evaluating the. Microbiologist jobs – New York. Experience as a public health microbiologist in.
Trainee jobs Public Health Sorted by Relevance ascending Government Jobs page has loaded. Job Description and Duties. Requirements for applying for trainee positions including the interview and selection process varies from.
Potential new hires into this classification are required to. Ad No Experience Required. The current median pay for a public health microbiologist is around 66000 annually although it can be slightly higher or lower depending upon educational background and experience.
Ad Its Time To Simplify Your Biotechnology Job Search. Friday December 3 2021The Animal Care Control Division within the Department of Public Health DPH is recruiting for Animal Control Officer Trainees who work in shelters and in the field to. County of San Bernardino San Bernardino CA.
35988 – 45924 a year. Public Health Microbiologist Trainee. All additional application materials as requested in the job announcement degreetranscripts certificates DD-214 if applicable ADA Accommodation Request.
3168 to 4348 Monthly. 82080 – 110616 a year.
 Public Health Microbiologist Training Caphld
Public Health Microbiologist Training Caphld
 Medical Microbiology Programme
Medical Microbiology Programme

The Complete Guide To Becoming A Medical Microbiologist Virologist
 Clinical Laboratory Scientist Program Scripps Health
Clinical Laboratory Scientist Program Scripps Health

 Public Health Microbiologist Training Caphld
Public Health Microbiologist Training Caphld

 Health And Medical Average Salaries In Spain 2021 The Complete Guide
Health And Medical Average Salaries In Spain 2021 The Complete Guide
 20 Best Microbiologist Resumes Resumehelp
20 Best Microbiologist Resumes Resumehelp
 Public Health Microbiologist Trainee What Is It And How To Become One
Public Health Microbiologist Trainee What Is It And How To Become One
 14 Career Paths For Microbiologists Microbiologics Blog
14 Career Paths For Microbiologists Microbiologics Blog
Job Announcement Public Health Microbiologist Trainee Extra Help Only County Of Solano
Job Announcement Public Health Microbiologist Trainee Extra Help Only County Of Solano
 Public Health Microbiologist Career Salary Job Description
Public Health Microbiologist Career Salary Job Description

 Public Health Microbiologist Career Salary Job Description
Public Health Microbiologist Career Salary Job Description

 Caphld Training And Job Opportunities
Caphld Training And Job Opportunities
 Caphld Training And Job Opportunities
Caphld Training And Job Opportunities